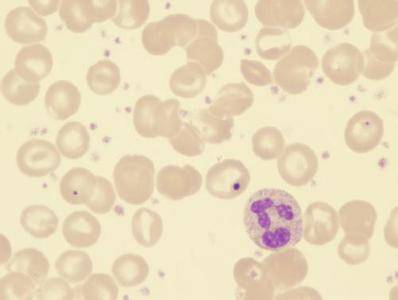

-
血小板生成素 编辑
血小板(blood platelet)是哺乳动物血液中的有形成分之一。形状不规则,比红细胞和白细胞小得多,无细胞核,成年人血液中血小板数量为100~300×10⁹个/L,它有质膜,没有细胞核结构,一般呈圆形,体积小于红细胞和白细胞。血小板在长期内被看作是血液中的无功能的细胞碎片。
中文名:血小板生成素
外文名:thrombopoietin
性质:哺乳动物血液中的有形成分
血小板具有特定的形态结构和生化组成,在正常血液中有较恒定的数量,在止血、伤口愈合、炎症反应、血栓形成及器官移植排斥等生理和病理过程中有重要作用。 血小板只存在于哺乳动物血液中。低等脊椎动物圆口纲有纺锤细胞起凝血作用,鱼纲开始有特定的血栓细胞。两栖、爬行和鸟纲动物血液中都有血栓细胞,血栓细胞是有细胞核的梭形成椭圆形细胞,功能与血小板相似。无脊椎动物没有专一的血栓细胞。 血小板为圆盘形,直径1~4微米到7一8微米不等,且个体差异很大(5~12立方微米)。血小板因能运动和变形,故用一般方法观察时表现为多形态。血小板结构复杂,简言之,由外向内为3层结构,即由外膜、单元膜及膜下微丝结构组成的外围为第1层;第2层为凝胶层,电镜下见到与周围平行的微丝及微管构造;第3层为微器官层,有线粒体、致密小体、残核等结构。
由骨髓造血组织中的巨核细胞产生。多功能造血干细胞在造血组织中经过定向分化形成原始的巨核细胞,又进一步成为成熟的巨核细胞。 成熟的巨核 细胞膜表面形成许多凹陷,伸入胞质之中,相邻的凹陷细胞膜在凹陷深部相互融合,使巨核细胞部分胞质与母体分开。最后这些被细胞膜包围的与巨核细胞胞质分离开的成分脱离巨核细胞,经过骨髓造血组织中的血窦进入血液循环成为血小板。新生成的血小板先通过脾脏,约有1/3在此贮存。贮存的血小板可与进入循环血中的血小板自由交换,以维持血中的正常量。每个巨核细胞产生血小板的数量每立方毫米大约200~8000,一般认为血小板的生成受血液中的血小板生成素调节,但其详细过程和机制尚不清楚。血小板寿命约7~14天,每天约更新总量的1/10,衰老的血小板大多在脾脏中被清除。
血小板的功能
血小板的功能主要是促进止血和加速凝血,同时血小板还有维护毛细血管壁完整性的功能。 血小板在止血和凝血过程中,具有形成血栓,堵塞创口,释放与凝血有关的各种因子等功能。在小血管破裂处,血小板聚集成血小板栓,堵住破裂口,并释放肾上腺素, 5-羟色胺等具有收缩血管作用的物质,是促进血液凝固的重要因子之一。 血小板还有营养和支持毛细血管内皮细胞的作用,使毛细血管的脆性减少。 血小板数量、质量异常可引起出血性疾病。数量减少见于血小板减少性紫癜,脾功能亢进,再生障碍性贫血和白血病等症。数量增多见于原发性血小板增多症、真性红细胞增多症等病症。质量异常可见于血小板无力症。 20世纪60年代以来已确证血小板有吞噬病毒、细菌和其他颗粒物的功能。血小板因能吞噬病毒而引人注目,在血小板内没有核遗传物质,被血小板吞噬的病毒将失去增殖的可能。临床上也见到患病毒性疾病时总出现血小板减少症。因此血小板有可能与皮肤, 粘膜和白细胞一样是构成机体对抗病毒的一道防线。
形态及其结构
血小板描述:细胞碎片,体积很小,形状不规则,常成群分布在红细胞之间。 循环血中正常状态的血小板呈两面微凹、椭圆形或圆盘形,叫做循环型血小板。人的血小板平均直径约2~4微米,厚0.5~1.5微米,平均体积7立方微米。血小板虽无细胞核,但有细胞器,此外,内部还有散在分布的颗粒成分。血小板一旦与创伤面或玻璃等非血管内膜表面接触,即迅速扩展,颗粒向中央集中,并伸出多个伪足,变成树突型血小板,大部分颗粒随即释放,血小板之间融合,成为粘性变形血小板。树突型血小板如及时消除其刺激因素还能变成循环型血小板,粘性变形的血小板则为不可逆转的改变。血小板有复杂的结构和组成。血小板膜是附着或镶嵌有蛋白质双分子层的脂膜,膜中含有多种糖蛋白,已知糖蛋白Ⅰb与粘附作用有关,糖蛋白Ⅱb/Ⅲa与聚集作用有关,糖蛋白Ⅴ是凝血酶的受体。血小板膜外附有由血浆蛋白、凝血因子和与纤维蛋白溶解系统有关分子组成的血浆层(血小板的外覆被)。血小板胞浆中有两种管道系统:与表面相连的开放管道系统和致密管系统。前者是血小板膜内陷在胞浆中形成的错综分布的管道系统,管道的膜与血小板膜相连续,管道膜内表面也有与血小板膜一样的外覆层,通过此管道系统,血浆可以进入血小板内部,从而扩大了血小板与血浆的接触面积,由于存在这套与表面相连的发达的管道系统,使血小板形成与海绵相似的结构;后者即致密管系统的管道细而短,与外界不通,相当内质网。血小板周缘的血小板膜下有十几层平行作环状排列的微管,近血小板膜处还有较密的微丝(肌动蛋白)和肌球蛋白,它们与血小板的形态的维持及变形运动有关。血小板内散在着两种颗粒:α颗粒和致密颗粒。α颗粒内容物是中等电子密度,有的颗粒中央还有电子密度较高的芯。α颗粒中含纤维蛋白原、血小板第4因子、组织蛋白酶A、组织蛋白酶D、酸性水解酶等。致密颗粒内容物电子密度极高,含有5-羟色胺、ADP、ATP、钙离子、肾上腺素、抗血纤维蛋白酶、焦磷酸等。另外,在血小板中还存在有线粒体、糖原颗粒等。
与白血病区别
血小板减少性紫癜病的典型症状表现为出血,在发病前期,皮肤会出现针扎样红点,之后会发展成块状血小板减少性紫癜,紫癜的大小不等,小的如黄豆粒,大的能达到手掌那么大。 出现血小板减少性紫癜的部位一般在体表皮肤比较松弛的部位,如颈部、眼睛周围、下肢等,并伴有肿痛,严重的会在口腔黏膜部位出现紫斑。血液中正常血小板数量为30万/立方毫米,患病时可减少到4万~5万,当血小板数量降至2万时,患者就有可能出现消化道出血、颅内出血、血尿等,甚至危及生命。 血小板减少性紫癜病跟白血病的一些症状相似,有些患者认为血小板减少性紫癜病就是种白血病,心理压力很大,其实完全没有必要。专家解释,认为紫癜病是因为单纯的血小板减少使凝血功能出现异常,而血小板减少和凝血功能异常只是白血病的症状之一,白血病患者体内的白细胞、红细胞等都不正常,它们完全是两码事.
血小板生成素-生物学作用
(1)生理调节造血祖细胞演化成成熟巨核细胞增殖和分化;
(2)与EPO一起相互协调,共同刺激原核细胞和红细胞的生成;共同促进骨髓抑制疗法后血小板和红细胞的恢复;
(3)TPO作为Mpl受体的配体,可防止血小板减少而不增加血栓闭塞并发症的危险。国外最新文献报道:急性白血病、骨髓增生异常综合症(MDS)、肝硬化、特发性血小板减少性紫癜患者TPO水平降低;再障患者TPO水平明显升高。
(4)TPO不仅能特异性的刺激巨核系祖细胞增殖分化,促进巨核细胞成熟,还能强烈促进核细胞或巨噬细胞和红系祖细胞的恢复,有诱导造血祖细胞动员进入外周循环的作用。TPO主要产生于肺和肾脏。血清游离 TPO浓度是通过黏附因子表达在人外周血血小板和巨核细胞上的c-mpl 来调节。亦有研究表明,TPO受体c-mpl在造血干细胞也普遍表达。多采用夹心酶-酶联免疫吸附试验(Sandwich-ELISA)法检测血清 TPO水平。
(5) 血小板生成素与血小板疾病关系密切,它的水平的检测对于血小板减少或增多的原因有鉴别诊断价值,而且可对某些疾病的药物治疗效果进行预测和评价。但是,TPO在某些疾病中的发病机制,代谢和调节,以及rhTPO的应用和副作用,都有待深入研究和进一步探讨
RNA印迹分析表明,人TPOmRNA在胎肝和成人肝脏以及肾脏有表达。肝和肾可能是TPO的主要产生部位。Sungaran等利用原位杂交检测了人类肾、肝、骨髓及脾中的TPOmRNA含量。分析表明,在正常人的骨髓中杂交信号很弱,而在患血小板减少症的个体骨髓基质细胞中有大量的TPOmRNA表达。在具有正常血小板数的个体中,位于肾小管近端的细胞中TPOmRNA有持续的表达,而肾小管远端细胞则无。在肝细胞中可测到强烈的杂交信号。而在脾中,即使是血小板减少症的个体,杂交信号也很弱。在所有的个体中,肝和脾的间质细胞和内皮细胞、肾小管外周细胞和骨髓的造血前体细胞都无TPOmRNA表达。这个结果表明人骨髓中TPOmRNA的表达可能是由血小板的数量来调节。Cohen-Solar等更证明,不仅血小板数量而且巨核细胞数量也对调节循环中的TPO水平起一定作用,TPOmRNA的量与血小板量成反比。
TPO主要的临床应用就是作为血小板减少症的治疗药物,特别是那些因化疗和放疗而导致的血小板减少症。
重组TPO在动物体内的实验表明,它不仅能比其它造血因子更有效地增加血小板水平,还具有促进其它造血细胞系活力的能力。Borge等也证实,TPO不仅能在体内外刺激巨核前体细胞的生长发育,增加其多倍性,还可以有效地促进骨髓前体细胞Lin-Sca-1+前体的活性,使其后代不仅具有生成巨核细胞的潜力,而且能生成为其它骨髓细胞系。可见,TPO将会大大减少化疗和骨髓移植的危险,有效治疗血小板减少症以及其它可能的相关病症。TPO将有广阔的应用前景。
重组人TPO(rhTPO)具有刺激巨核细胞生成的作用。有人使用rhTPO 治疗血小板减少性疾病,发现rhTPO治疗组血小板最低值明显高于安慰剂对照组,且血小板数恢复正常的时间明显缩短,作用与剂量相关,并且未见严重副反应发生和血小板形态及功能异常。但是,在实验中发现急性髓性白血病(AML)患者中的未成熟细胞异常显示TPO受体(mpl)。由此认为,rhTPO可引起部分未成熟细胞增生扩散,因而在AML患者中应慎重应用。
1、本站所有文本、信息、视频文件等,仅代表本站观点或作者本人观点,请网友谨慎参考使用。
2、本站信息均为作者提供和网友推荐收集整理而来,仅供学习和研究使用。
3、对任何由于使用本站内容而引起的诉讼、纠纷,本站不承担任何责任。
4、如有侵犯你版权的,请来信(邮箱:baike52199@gmail.com)指出,核实后,本站将立即删除。